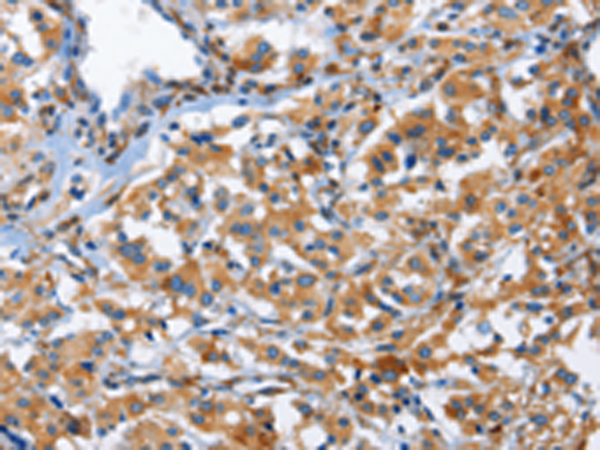

-
分类: 科研抗体货号: P01238别名: ASPS; HCKID; FASPS2; CKIdelta应用: IHC反应种属: Human, Mouse, Rat
-
分类: 科研抗体货号: P01183别名: 2B4; NAIL; Nmrk; NKR2B4; SLAMF4应用: WB,IHC反应种属: Human, Mouse
-
分类: 科研抗体货号: P01231别名: NAR; NEB1; CPSF30应用: IHC反应种属: Human, Mouse, Rat
-
分类: 科研抗体货号: P01182别名: AU; LU; CD239; MSK19应用: WB,IHC反应种属: Human, Mouse
-
分类: 科研抗体货号: P01228别名:应用: WB,IHC反应种属: Human, Mouse, Rat
-
分类: 科研抗体货号: P01181别名: CD23; FCE2; CD23A; IGEBF; CLEC4J; BLAST-2应用: IHC反应种属: Human
-
分类: 科研抗体货号: P01225别名: MED; EDM1; EPD1; PSACH; THBS5应用: WB,IHC反应种属: Human, Mouse, Rat
-
分类: 科研抗体货号: P01175别名: CD170; OBBP2; CD33L2; OB-BP2; SIGLEC-5应用: IHC反应种属: Human
-
分类: 科研抗体货号: P01224别名: CERT; GPBP; CERTL; MRD34; STARD11; COL4A3BP应用: WB,IHC反应种属: Human, Mouse
-
分类: 科研抗体货号: P01174别名: NKR; CD161; CLEC5B; NKR-P1; NKRP1A; NKR-P1A; hNKR-P1A应用: WB,IHC反应种属: Human, Mouse

鄂公网安备42018502007531号
鄂公网安备42018502007531号

